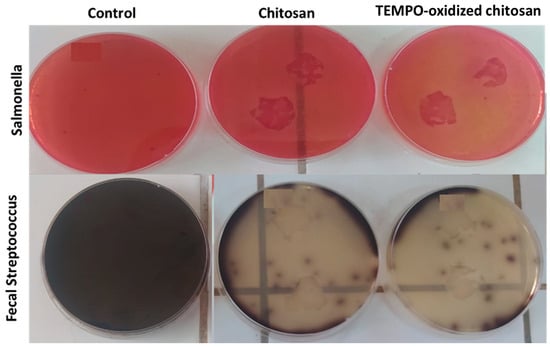

Abstract
This study systematically investigated the oxidation of chitosan using the TEMPO/NaClO/NaBr catalytic system under varying experimental conditions, namely temperature, reaction time, and pH, in order to optimize the oxidation process. Response surface methodology (RSM) was employed to determine the optimal parameters for maximizing the efficiency of the reaction. The structural modifications to the chitosan following oxidation were confirmed using Fourier-transform infrared spectroscopy (FTIR), alongside additional analytical techniques, which validated the successful introduction of carbonyl and carboxyl functional groups. Solvent-cast films were prepared from both native and oxidized chitosan in order to evaluate their functional performance. The antibacterial activity of these films was assessed against Gram-negative (Salmonella) and Gram-positive (Streptococcus faecalis) bacterial strains. The oxidized chitosan films exhibited significantly enhanced antibacterial effects, particularly at shorter incubation periods. In addition, antioxidant activity was evaluated using DPPH radical scavenging and ferrous ion chelation assays, which both revealed a marked improvement in radical scavenging ability and metal ion binding capacity in oxidized chitosan. These findings confirm that TEMPO-mediated oxidation effectively enhances the physicochemical and bioactive properties of chitosan, highlighting its potential for biomedical and environmental applications.
1. Introduction
Today, packaging materials represent a major challenge for the modern food industry. Innovation in this field has become essential due to the growing consumer demand for high-quality food that is free from chemical preservatives. Integrating antimicrobial and antioxidant properties into packaging materials is emerging as a promising strategy to extend food shelf life and enhance food safety. These compounds, incorporated directly into packaging matrices, help maintain an effective concentration of preservatives on the surface of foodstuffs, as noted by Fadiji et al. [1] and Periyasamy et al. [2]. Among the emerging solutions, bio-based packaging materials are a novel alternative, capable of improving food quality while extending shelf life. These materials act as effective barriers against oxygen, humidity, aromas, flavors, and fats [3,4]. In addition, biopolymer-based films provide an excellent support for the incorporation of various functional additives: antimicrobial agents, antioxidants, antifungals, colorants, or even nutrients [5]. This so-called “active” packaging is thus attracting growing interest in the food industry, particularly for the preservation of meat, poultry, cereals, cheese, fruit, and vegetables [6]. Among these biopolymers, chitosan—a linear polysaccharide consisting of 2-amino-2-deoxy-β-D-glucan—occupies a prominent place. According to Ahmad Dar et al. [7], it is the second most abundant natural polysaccharide after cellulose. Its use in the production of biodegradable films is well documented, particularly due to its antimicrobial, antioxidant, and antifungal properties [8], which help to preserve the nutritional quality of food. However, chitosan-based films suffer from certain limitations, including low mechanical strength and relatively high permeability to gases and water vapor, limiting their use as a single solution in food packaging. However, as previously reported by Devi et al. [9], due to the presence of many reactive functional groups, such as amino and hydroxyl groups, chitosan can easily undergo various chemical modifications (carboxylation, acylation, alkylation, etc.) in order to improve its solubility in water and expand its applications. One such modification of great interest is the oxidation at the C-6 position of chitosan, as shown in the work of Yadav et al. [10].
The selective oxidation of chitosan using the TEMPO/NaOCl/NaBr catalytic system, carried out in a homogeneous aqueous medium, is a promising approach to improving its physicochemical properties, in particular its antioxidant activity. Following this process with ultrasonication treatment allows for the selective conversion of hydroxyl groups (−OH) into aldehydes (−CHO), then into carboxylates (−COO−). The resulting oxidized derivative, commonly referred to as TEMPO-oxidized chitosan, exhibits enhanced functional characteristics. As reported by Isogai et al. [11] and Kartik et al. [12], such modifications substantially increase the molecule’s reactivity and solubility, making it a promising candidate for the development of bio-sourced films with improved antioxidant efficiency. These films are particularly well suited for use in active food packaging applications aimed at extending shelf life and improving food safety.
In recent years, TEMPO-mediated oxidation has gained interest as one of the most efficient and selective methods for modifying polysaccharides, particularly through the conversion of primary hydroxyl groups at the C-6 position into aldehyde and carboxyl groups. While several studies, including that of Kato et al. [13], have previously examined the effects of individual parameters such as pH, reaction time, and temperature on the oxidation process, these investigations were generally performed using classical experimental designs that are limited in efficiency and interaction assessment. Thus, the true novelty of the present study lies not in being the first to examine these parameters, but rather in the system of its response surface method approach, which allows for a more efficient and statistically robust optimization process. We hypothesize that optimizing the conditions of TEMPO-mediated oxidation using RSM will significantly enhance both the yield and the functional performance of oxidized chitosan films, particularly their antioxidant and antibacterial activities.
The objective of this study is to optimize the experimental conditions (reaction time, temperature, and pH) of the TEMPO-mediated oxidation of chitosan in order to maximize the yield of oxidized chitosan. To achieve this, response surface methodology was applied. Additionally, the structure of films prepared from native and oxidized chitosan was characterized, and their antioxidant and antibacterial activities were evaluated against Gram-negative bacteria (Salmonella) and Gram-positive (Streptococcus faecalis) bacteria.
2. Materials and Methods
2.1. Chitosan Preparation
Chitosan (CTS) was prepared by deacetylation of chitin extracted from shrimp shells obtained from local fishmongers. The shells were first cleaned, dried, and ground. The resulting powder was subjected to a demineralization step using three successive baths of dilute hydrochloric acid (1.5 M) at room temperature, each lasting 1 to 2 h, with a solid-to-liquid ratio of 1:10 (w/v). After each bath, the material was filtered and washed with distilled water until a neutral pH was reached. Following demineralization, deproteinization was performed to remove protein components bound to chitin as chitin–protein complexes. This step involved treatment with a 1.5 M sodium hydroxide (NaOH) solution at 80 °C for 1 to 2 h, also using a 1:10 (w/v) solid-to-liquid ratio. The deproteinization was repeated across three successive baths to ensure the thorough removal of residual proteins. The resulting purified chitin was then deacetylated by two successive treatments using a 50% (w/w) NaOH solution, preheated to 120 °C, for 24 h each. This high-concentration alkaline treatment enabled the conversion of chitin into chitosan by removing acetyl groups from the polymer backbone. The degree of deacetylation (DD), the molecular weight (MW), and the degree of polymerization (DP) of the prepared chitosan were measured in accordance with the experimental procedures detailed elsewhere [14,15,16]. The results are shown in Table 1. Figure 1A shows a typical X-ray diffraction pattern of the prepared chitosan.

Table 1.
Physical characteristics of the synthesized chitosan.

Figure 1.
(A) X-ray diffraction traces of the chitosan (CTS) used. (B) The film preparation procedure.
2.2. Preparation of TEMPO-Oxidized Chitosan
Chitosan oxidation was performed using the TEMPO/NaClO/NaBr system, following a modified procedure of Muzzarelli et al. [17], with three different parameters: temperature, reaction time, and pH. The protocol involves preparing an aqueous suspension of chitosan (2% w/w) to which TEMPO (156 mmol/mol of glucosamine), NaBr (0.789 mol/mol), and sodium hypochlorite (NaClO, 52.868 mol/mol) are successively added, the latter being the main oxidizing agent. The reaction takes place in a basic medium, which is maintained by the continuous addition of sodium hydroxide (1 M NaOH), which is an essential condition for the system to be efficient. Oxidation is stopped by adding methanol, which inactivates the active radicals. The pH is then adjusted to 7 to stabilize the product. The oxidized chitosan is then recovered by centrifugation at 11,000 rpm for 30 min and purified by successive washes with distilled water.
2.3. Determination of Carboxylate Content and Oxidation Degree
The carboxylate content and the degree of oxidation (OD) of the TEMPO-oxidized chitosan were determined using conductometric and potentiometric methods described elsewhere [18]. The following equation was used for OD determination [19]:
where V1 and V2 are the volumes (L) of NaOH solution required to neutralize strong acid, HCl, and the weak acid, oxidized chitosan; w is the weight (g) of the sample.
2.4. Preparation of the Films
A 1% aqueous solution of acetic acid (25 mL) and either 250 mg of chitosan or TEMPO-oxidized chitosan was prepared and stirred separately for two hours at room temperature. The two solutions were then poured into a glass Petri dish and left at room temperature until the water had completely evaporated. The resulting film was immersed in a 0.5 M NaOH solution, thoroughly washed with distilled water, and stored at 25 °C. A schematic representation of the procedure is shown in Figure 1B.
2.5. Optimization of the Effects of the Operating Factors of Chitosan Oxidation Through Doehlert Design
The effects of temperature, the duration of the chemical treatment, and pH on TEMPO-oxidized chitosan were evaluated using the following quadratic model:
where a0, ai, aii, and aij are model constants: ai represents the “i” factor weight; aii is a curve shape parameter; and aij expresses the weight of the effect of the interaction between the “i” and “j” factors. Xi is the coded variable related to the real value (vi) of factor “i”, according to the following equation:
where vio is the central value of factor iii, and Δvi is the step variation. The investigated domains for each factor were as follows: −5 ≤ T ≤ 40 °C; 48 ≤ t ≤ 282 min; and 9 ≤ pH ≤ 11. Δvi is the step variation:
- √
- Temperature (T): −5 ≤ T ≤ 40 °C with ΔvT = 22.5,
- √
- Duration (t): 48 ≤ t ≤ 282 min with Δvt = 135,
- √
- pH: 9 ≤ pH ≤ 11 with ΔvpH = 1.
The coded variables X1, X2, and X3 correspond to temperature (T), duration (t), and pH, respectively.
The model constants were determined using the Doehlert matrix and the least squares regression method [20]. The experimental conditions defined by Doehlert and the degree of oxidation measured in these conditions are given in Table 2. The validity of the model was assessed by ANOVA results [21].

Table 2.
Planned experiments (Doehlert matrix design) and the measured values of the response (OD).
2.6. Characterization Techniques
Fourier-transform infrared analysis was conducted on thin discs in the range of 4000–400 cm−1 using a Perkin-Elmer Fourier-Transform 1720-x-spectrophotometer.
The X-ray diffraction (XRD) analysis was performed on powder samples using a Philips X’Pert MPD diffractometer operating with a copper anode (λKα = 1.5418 Å). The step size (°2θ) and the scan step time were set at 0.013 and 1 s, respectively.
2.7. Antibacterial and Antifungal Assay
The antibacterial activity of chitosan and its oxidized derivative was evaluated against two pathogenic bacterial strains: Salmonella (Gram-negative) and Streptococcus faecalis (Gram-positive). Disk susceptibility tests were performed, as these bacteria are among the most common pathogenic strains. The bacterial cultures were grown on sterilized nutrient agar in Petri dishes. The discs (~2 cm diameter) cut from the films were sterilized by using an autoclave, and by immersion in ethanol (99%), followed by exposure to UV radiation. The sterilized discs were placed on the inoculated medium and incubated at 37 °C for 24 h.
The antibacterial activity of the films was evaluated by determining the percentage of inhibition (PI) of the two bacterial strains. For this purpose, the bacterial suspension was adjusted to 105–106 CFU/mL in sterile saline solution (0.9% w/v). A 9 cm2 film sample was placed into a tube containing 5 mL of nutrient broth and sterilized by autoclaving at 120 °C for 20 min. The tube was then inoculated with 0.5 mL of the bacterial suspension and incubated at 37 °C for 24 h. The optical density (OD) of the incubated and the original (blank) suspensions was measured using a UV-visible spectrophotometer operating at 620 nm [22]. These data were used to calculate the percentage of inhibition PI:
Concerning the kinetics of the antibacterial activity, 1 mL of the bacterial suspension (approximately 106 CFU/mL) was taken and added to 10 mL of a chitosan solution (either native or TEMPO-oxidized) at a concentration of (1 mg/mL) in an appropriate buffer (acetic acid adjusted to pH = 6.5). The mixture was then incubated at 37 °C for different contact times: 30 min, 1 h, 2 h, 4 h, and 8 h. After each incubation period, 1 mL of the treated suspension was withdrawn ,washed with sterile saline solution (0.85% NaCl), and resuspended. Then, 100 µL of the bacterial suspension was spread or flooded onto Petri dishes containing nutrient agar. The plates were incubated at 37 °C for 24 h, and the number of viable colonies was counted. Results were expressed as colony-forming units per milliliter (CFU/mL) and compared to control samples without chitosan treatment to assess the antibacterial efficacy over time.
2.8. Antioxidant Activity
2.8.1. DPPH Radical Scavenging Assay
The method reported by Mansouri et al. [23] was used to assess the antioxidant capacity. A volume of 25 µL of the extracts at various concentrations was combined with 975 µL of a methanolic solution of DPPH (6 × 10−5 M). The mixture was then incubated in the dark at a temperature of 25 °C for 30 min. Absorbance was measured at 517 nm. Trolox was used as a positive control. The percentage inhibition (I%) was calculated using the following equation:
DPPH free radical scavenging activity is measured in terms of percentage inhibition at 50% (IC50 mg/mL).
2.8.2. Ferrous Ion Chelating Assay
According to Liyana-Pathirana et al. [24], the activity is measured using a method based on the inhibition of the formation of the Fe (II)–Ferrozine complex. To perform this test, 400 µL of the sample or a reference chelator (EDTA) was mixed with 285 µL of distilled water and 275 µL of FeCl2-4H2O (0.2 mM). Five minutes after incubation, 40 µL of ferrozine (5 mM) was added to the mixture, which was then shaken and incubated for a further 10 min. Absorbance was measured at 562 nm. The chelating activity was expressed as a percentage using the following equation:
The ferrous ion chelation capacity is expressed as IC50 (mg/mL).
2.8.3. ABTS Radical Scavenging Assay
The antiradical activity of ABTS was measured using the Re et al. method [25]. ABTS+ radical cations were generated by creating a reaction between an aqueous solution of ABTS (7 mM) and an aqueous solution of potassium persulfate (2.45 mM). The mixture was left in the dark at room temperature for 12 to 16 h before use. It was then diluted with distilled water to achieve an absorbance of 0.700 ± 0.005 at 734 nm. Next, 30 µL of the sample or Trolox at various concentrations was added to 3 mL of the ABTS radical solution. The mixture was kept at room temperature for 6 min, after which the absorbance at 734 nm was measured. Activity was determined by calculating the IC50 value (mg/mL).
3. Results and Discussion
3.1. Structural Characterization of the Films
The FT-IR spectra presented in Figure 2 provide strong evidence for the successful oxidation of native chitosan, as indicated by the appearance and disappearance of characteristic vibrational bands. Notably, a decrease in the absorption band around 2880 cm−1, corresponding to C–H stretching vibrations of –CH2 groups, indicates a modification to the chitosan backbone structure. This suggests that the primary hydroxyl groups at the C-6 position of the glucosamine units were oxidized to carboxyl groups during the TEMPO-mediated oxidation process [26,27]. Furthermore, the appearance of a new absorption band at 1626 cm−1 [26,27] corresponds to the asymmetric stretching vibration of carboxylate anions (–COO−). This confirms the introduction of carboxylic acid functionalities into the oxidized chitosan structure. The emergence of this band is a typical spectral signature of TEMPO-oxidized chitosan, where the selective oxidation of the primary alcohol at C-6 leads to the formation of carboxyl groups, while preserving the integrity of the β-(1→4)-linked glucosamine backbone largely intact. Due to the adopted chemical treatment, it should be noted that the intensity of the band associated with NH3+ significantly decreased, and the assignment of the FT-IR bands shown in Figure 2 is provided in Table 3. The complete assignment of the main FT-IR bands, including those corresponding to the hydroxyl, amine, and carboxyl groups, is provided in Table 3.

Figure 2.
FT−IR spectra of the studied films.

Table 3.
Frequencies (cm−1) and FT-IR band assignments of spectra of films based on pure chitosan and oxidized chitosan.
3.2. Evaluation of the Effects of the Studied Factors on the Degree of Oxidation of Chitosan
Based on the ANOVA results given in Table 4, particularly the high Fisher value and the low significance value (<0.05), the following model applies:

Table 4.
ANOVA results and adjusted root square values associated with the adopted polynomial models.
The variation in oxidation degree (OD) with respect to the studied factors is clearly illustrated. The validity of the model is supported by a high adjusted coefficient of determination (R2_adj = 0.989), as well as by the residual distribution (Figure 3).

Figure 3.
Probability plot of residuals provided by the software used.
Considering the linear terms of the model, OD increased with rising values of duration (t), temperature (T), and pH; the relative impact of these factors followed the order: t > T > pH. Based on the model data, antagonistic interactions were observed between T and t as well as between T and pH (Figure 4). In contrast, a synergetic interaction should be observed between t and pH, with the most significant interaction occurring between pH and t.

Figure 4.
Three-dimensional and two-dimensional representations of the variation of oxidation degree as a function of the factors studied.
The results of the optimization study showed that the optimal OD value, found to be 80%, was achieved under the following experimental conditions: T = 28 °C, duration = 238 min, and pH = 11. The oxidation reaction by TEMPO is sensitive to operating conditions such as temperature, pH, and duration. The TEMPO-oxidized chitosan obtained under these optimal conditions was further investigated in subsequent analyses.
The oxidation of primary alcohols into carboxylic acids using the TEMPO system is well documented in the literature. This process involves a catalytic cycle that requires a strongly basic medium (typically pH ≈ 10–11).
However, it is also well established that chitosan is susceptible to depolymerization through glycosidic bond cleavage under such prolonged alkaline and oxidative conditions. To assess this risk, the degree of polymerization (DP) of the oxidized chitosan was estimated by intrinsic viscosity measurements. The resulting value, approximately 930, is close to that of native chitosan, suggesting that no significant degradation of the macromolecular structure occurred.
3.3. Comparison of Antioxidant Activities
A number of in vitro techniques have been developed to evaluate the antioxidant efficacy of fruits. In this study, the antioxidant capacity of chitosan and TEMPO-oxidized chitosan was evaluated using three tests: (1) The DPPH (2,2-diphenyl-1-picrylhydrazyl) radical scavenging test, which measures the decrease in absorbance of the violet chromogenic radical 2,2-diphenyl-1-picrylhydrazyl (DPPH), which is reduced by antioxidant compounds to pale yellow hydrazine, with a maximum absorption at 517 nm [28,29]. (2) The ferrous ion (Fe2+) chelation test, which is based on inhibiting the formation of the Fe2+–ferrozine complex, which is measured by the absorbance of the complex at 562 nm [30,31]. (3) The ABTS+ radical test, which is based on the reduction of the ABTS+ radical, resulting in a change in color from blue-green to lighter shades or transparency, depending on the effectiveness of the antioxidant in neutralizing free radicals [32]. The antioxidant power is expressed by the 50% inhibition concentration of chitosan and TEMPO-oxidized chitosan extracts, as shown in Figure 5.

Figure 5.
Antioxidant capacity of chitosan and TEMPO-oxidized chitosan, assessed by three tests: Trolox: 3,4-dihydro-6-hydroxy-2,5,7,8-tétraméthyl-2H-1-benzopyran-2-carboxylique; EDTA: ethylenediamine tetraacetic acid; and ABTS: 2,2′-azinobis-(3-ethylbenzothiazoline-6-sulfonic acid). Means sharing the same letters are not significantly different at p < 0.01, as determined by the Tukey test.
The DPPH and ABTS tests, and the capacity to chelate ferrous ions, are expressed as IC50 values (the concentration of extract required to inhibit 50% of the initial DPPH radical) in mg/mL. The respective antioxidant capacities of chitosan are 4.5 mg/mL, 0.29 mg/mL, and 0.66 mg/mL, respectively. On the other hand, TEMPO-oxidized chitosan showed a higher antioxidant activity, with IC50 values of 1.13 mg/mL, 0.14 mg/mL, and 0.45 mg/mL, respectively. The difference observed between the two types of chitosan was significant (p < 0.01), indicating that chitosan was less active than TEMPO-oxidized chitosan. Additionally, chitosan activity was significantly (p < 0.01) lower than that of the positive controls (Trolox for the DPPH test and the ABTS and EDTA positive controls for ferrous ion chelation capacity) for all three tests. By contrast, the activity of TEMPO-oxidized chitosan was close to that of the positive controls, particularly for the ABTS test, for which the difference in activity between the two was not significant (p > 0.05).
The antioxidant activity of our sample in the DPPH radical scavenging test is higher than that observed in a previous study, where the IC50 values were all between 9.13 and 20.0 mg/mL. This suggests that the crab chitosan in the previous study was less active than our chitosan. In the ferrous ion chelation test, the IC50 values found in our study are consistent with those reported in the aforementioned study, ranging from 0.57 to 0.68 mg/mL [33].
Another study found IC50 values of 1.65 mg/mL [34], which are lower than those of our chitosan sample. This means that the activity of our chitosan is lower than that reported in this study. However, However, the TEMPO-oxidized chitosan prepared in the same study [34] is higher than that of the same chitosan reported in this study. The same study found that the activity against 2,2′-azino-bis(3-ethylbenzothiazoline-6-sulphonic acid) (ABTS), as measured by IC50 was 2.8 mg/mL, which is much higher than our results. This indicates that both chitosan and TEMPO-oxidized chitosan exhibit high antioxidant activity against the ABTS radical [35], confirming that preparing this chitosan-based TEMPO-oxidized chitosan complex makes it more active.
Ivashkiv et al. [36] emphasized that the ion-chelation capacity of chitosan is governed by multiple structural factors. They proposed that the chelation of divalent metal ions such as Cu2+ primarily involves interactions with the hydroxyl group at the C6 position and the amino group at the C2 position of the chitosan backbone. A similar mechanism likely applies to Fe2+ chelation, with both functional groups participating in the coordination process. Furthermore, previous findings by Yen et al. [33] demonstrated the critical role of the degree of acetylation in determining the chelating efficiency of chitosan. Their study revealed that fully acetylated chitosan exhibits significantly reduced chelation activity, likely due to the diminished availability of free amino groups. These insights support the observed enhancement in metal-binding ability following TEMPO-mediated oxidation, which modifies the hydroxyl groups without impairing the amine functionalities, thereby preserving or even improving the chelation potential.
Our oxidized chitosan exhibits an improved oxidation state of 80% and significantly higher antioxidant capacity, as shown by the IC50 values obtained in DPPH, ABTS, and ferrous ion chelation tests. These findings demonstrate that our oxidation process not only optimizes the chemical modification of chitosan but also improves its functional properties compared to previous studies [27,37], thus highlighting the superiority and originality of our approach.
The results obtained concerning the antioxidant properties of chitosan and TEMPO show that these two materials can be used as a source of antioxidants, for example, in food supplements, food products, or pharmaceuticals.
3.4. Biological Evaluation
3.4.1. Antimicrobial Assay
The results of the antimicrobial activity tests on the native and TEMPO-oxidized chitosan films (Figure 6) reveal an absence of distinct inhibition zones around the discs, while clear zones are observed directly below. This suggests that both films primarily exert their antibacterial effects through contact mechanisms rather than by releasing active agents into the surrounding environment. However, as the visual differences between the two films are subtle in the inhibition zone images, a more detailed assessment of their antibacterial efficacy is provided in the subsequent kinetic study.
Figure 6.
Inhibition zone experiment of films studied against bacterial strains.
3.4.2. Kinetics of the Growth Inhibition of the Bacteria and Antimicrobial Tests
Kinetic studies indicate that with Streptococcus faecalis, the inhibitory effect is immediate upon contact. The inhibition rate (PI) of Streptococcus faecalis growth by chitosan and functionalized chitosan films is 100% after 30 min of incubation.
For Salmonella, near-total inhibition is observed after 6 h of contact with native chitosan, and after a shorter duration (4 h) with functionalized chitosan.
According to the kinetic curves (Figure 7), the inhibition rate (PI) of Salmonella growth on chitosan films ranges from 82% to 92% after 8 h of incubation, whereas for functionalized chitosan, it reaches between 82% and 98% after just 2 h.

Figure 7.
Kinetic curves associated with the inhibition of the growth of Salmonella strains studied in the films.
The kinetics of bacterial growth inhibition follow a pseudo-first-order equation:
where (PI)t and (PI)e are the instantaneous and equilibrium percentages of growth inhibition of the bacterial strains, respectively, and k and t are the respective rate and time constants.
The estimated value of k for Salmonella is 0.658 s−1 for the chitosan film, and for the functionalized chitosan film, k is estimated at 0.98 s−1. Based on the linear evolution of the PI = f (√time) (not shown) curves, the inhibition kinetics are mainly controlled by the diffusion process, which appears to be affected by the environment closest to the cells (boundary layer). This diffusion process likely involves the leakage of vital intracellular substances, as the interaction between chitosan and its oxidized derivative with the negatively charged outer membrane of the bacteria affects its permeability.
Chemical modification of chitosan improves the inhibitory effect; the best inhibition rate for shorter incubation times is observed with functionalized chitosan. It should also be noted that Streptococcus bacteria, belonging to the Gram-positive category, are more sensitive to the antibacterial activity of chitosan and its functionalized derivative. Indeed, lipoteichoic acid, which is a constituent of the cell wall of the Gram-positive bacteria, such as Streptococcus faecalis, can quickly interact with chitosan and TEMPO-oxidized chitosan, resulting in a disturbance to cell membrane function. The accumulation of chitosan around the cell wall may hinder the entry of nutrients and the release of waste products by the cell. Consequently, the metabolism of the cell is drastically altered.
4. Conclusions
This study demonstrates the effectiveness of TEMPO-mediated oxidation in enhancing the functional and physicochemical properties of chitosan for potential applications in active food packaging. Using response surface methodology (RSM), the influence of the key parameters of reaction time, temperature, and pH on the oxidation process was systematically investigated and optimized. The resulting mathematical model identified optimal conditions that significantly improved the yield of oxidized chitosan. Evaluation of the antioxidant properties using DPPH radical scavenging and ferrous ion chelation assays revealed that TEMPO-oxidized chitosan exhibits superior radical neutralization and metal ion binding capabilities compared to native chitosan. Furthermore, antimicrobial tests against both Gram-negative (Salmonella) and Gram-positive (Streptococcus faecalis) bacterial strains showed that oxidized chitosan exhibits increased antibacterial activity, particularly during the early stages of exposure.
The observed functional improvements in oxidized chitosan are consistent with the high degree of oxidation achieved under optimal conditions (DO ≈ 80%). The introduction of a carboxyl group significantly enhances the electron-donating capacity of chitosan, which explains the improved radical-scavenging activity observed in DPPH and ABTS assays. Furthermore, the increased presence of negatively charged functional groups likely promotes stronger electrostatic interactions with positively charged sites on bacterial membranes, contributing to improved antimicrobial efficacy.
In conclusion, optimized TEMPO-mediated oxidation of chitosan offers a promising approach to enhance the functionality of this natural biopolymer in environmentally friendly and health-conscious food packaging systems. Future research may focus on scaling up the process, evaluating the mechanical and barrier properties of the films, and assessing their performance in real food packaging applications.
Author Contributions
A.M. and A.A.: Conceptualization, A.M. and A.A.: methodology, A.A.-K.: software, A.O. and A.B.: validation, M.O. and M.E.H.B.: formal analysis, A.M.; investigation, A.M.: writing—original draft preparation, A.A. and N.E.: supervision. All authors have read and agreed to the published version of the manuscript.
Funding
This research received no external funding.
Institutional Review Board Statement
Not applicable.
Data Availability Statement
Data are contained within this article.
Conflicts of Interest
The authors declare that they have no known competing financial interests or personal relationships that could have appeared to influence the work reported in this paper.
Abbreviations
The following abbreviations are used in this manuscript:
| TEMPO | 2,2,6,6-Tetramethylpiperidin-1-yl oxy |
| NaClO | Sodium hypochlorite |
| NaBr | Sodium bromide |
References
- Fadiji, T.; Rashvand, M.; Daramola, M.O.; Iwarere, S.A. A review on antimicrobial packaging for extending the shelf life of food. Processes 2023, 11, 590. [Google Scholar] [CrossRef]
- Periyasamy, T.; Asrafali, S.P.; Lee, J. Recent Advances in Functional Biopolymer Films with Antimicrobial and Antioxidant Properties for Enhanced Food Packaging. Polymers 2025, 17, 1257. [Google Scholar] [CrossRef]
- Perera, K.Y.; Jaiswal, A.K.; Jaiswal, S. Biopolymer-Based Sustainable Food Packaging Materials: Challenges, Solutions, and Applications. Foods 2023, 12, 2422. [Google Scholar] [CrossRef]
- Khalid, M.Y.; Arif, Z.U. Novel biopolymer-based sustainable composites for food packaging applications: A narrative review. Food Packag. Shelf Life 2022, 33, 100892. [Google Scholar] [CrossRef]
- Karnwal, A.; Kumar, G.; Singh, R.; Selvaraj, M.; Malik, T.; Al Tawaha, A.R.M. Natural biopolymers in edible coatings: Applications in food preservation. Food Chem. X 2025, 25, 102171. [Google Scholar] [CrossRef]
- Gupta, D.; Lall, A.; Kumar, S.; Patil, T.D.; Gaikwad, K.K. Plant based edible films and coatings for food packaging applications: Recent advances, applications, and trends. Sustain. Food Technol. 2024, 2, 1428–1455. [Google Scholar] [CrossRef]
- Ahmad Dar, S.; Abd Al Galil, F.M. Biodegradation, biosynthesis, isolation, and applications of chitin and chitosan. In Handbook of Biodegradable Materials; Springer International Publishing: Cham, Switzerland, 2022; pp. 1–42. [Google Scholar]
- Flórez, M.; Guerra-Rodríguez, E.; Cazón, P.; Vázquez, M. Chitosan for food packaging: Recent advances in active and intelligent films. Food Hydrocoll. 2022, 124, 107328. [Google Scholar] [CrossRef]
- Devi, N.; Bansal, N.; Sharma, S.; Dubey, S.K.; Kumar, S. Novel chitosan-based smart bio-nanocomposite films incorporating TiO2 nanoparticles for white bread preservation. Int. J. Biol. Macromol. 2024, 267, 131367. [Google Scholar]
- Yadav, M.; Kaushik, B.; Rao, G.K.; Srivastava, C.M.; Vaya, D. Advances and challenges in the use of chitosan and its derivatives in biomedical fields: A review. Carbohydr. Polym. Technol. Appl. 2023, 5, 100323. [Google Scholar] [CrossRef]
- Isogai, A.; Hänninen, T.; Fujisawa, S.; Saito, T. Catalytic oxidation of cellulose with nitroxyl radicals under aqueous conditions. Prog. Polym. Sci. 2018, 86, 122–148. [Google Scholar] [CrossRef]
- Kartik, R.; Muthusamy, S.; Shelly, K.; Surendiran, M. Chemical Modifications of Chitin and Chitosan Fibers and Filaments: A Review. Macromol. Chem. Phys. 2025, 226, 2400422. [Google Scholar] [CrossRef]
- Kato, Y.; Kaminaga, J.; Matsuo, R.; Isogai, A. TEMPO-mediated oxidation of chitin, regenerated chitin and N-acetylated chitosan. Carbohydr. Polym. 2004, 58, 421–426. [Google Scholar] [CrossRef]
- Tolaimate, A.; Desbrieres, J.; Rhazi, M.; Alagui, A. Contribution to the preparation of chitins and chitosans with controlled physico-chemical properties. Polymer 2003, 44, 7939–7952. [Google Scholar] [CrossRef]
- Brugnerotto, J.; Lizardi, J.; Goycoolea, F.M.; ArguÈelles-Monal, W.; DesbrieÁres, J.; Rinaudo, M. An infrared investigation in relation with chitin and chitosan characterization. Polymer 2001, 42, 3569–3580. [Google Scholar] [CrossRef]
- Kumar, M.N.V.R. A review of chitin and chitosan applications. React. Funct. Polym. 2000, 46, 1–27. [Google Scholar] [CrossRef]
- Muzzarelli, R.A.; Rocchetti, R. Determination of the degree of acetylation of chitosans by first derivative ultraviolet spectrophotometry. Carbohydr. Polym. 1985, 5, 461–472. [Google Scholar] [CrossRef]
- da Silva, S.B.; Batista, G.L.; Santin, C.K. Chitosan for sensors and electrochemical applications. In Chitin and Chitosan: Properties and Applications; van den Broek, L.A.M., Boeriu, C.G., Eds.; John Wiley & Sons: Hoboken, NJ, USA, 2019; pp. 461–476. [Google Scholar]
- Delattre, C.; Rios, L.; Laroche, C.; Le, N.H.T.; Lecerf, D.; Picton, L.; Berthon, J.Y.; Michaud, P. Production and characterization of new families of polyglucuronic acids from TEMPO-NaOCl oxidation of curdlan. Int. J. Biol. Macromol. 2009, 45, 458–462. [Google Scholar] [CrossRef] [PubMed]
- Sousa Filho, H.R.; Oliveira, D.M.; Lemos, V.A.; Bezerra, M.A. Evaluation of Two Statistical Tools (Least Squares Regression and Artificial Neural Network) in the Multivariate Optimization of Solid-Phase Extraction for Cadmium Determination in Leachate Samples. J. Braz. Chem. Soc. 2015, 26, 40–50. [Google Scholar] [CrossRef]
- Resendiz-Moctezuma, C.; Fonville, A.P.; Harsh, B.N.; Stasiewicz, M.J.; Miller, M.J. Use of Doehlert Matrix as a Tool for High-Throughput Screening of Organic Acids and Essential Oils on Miniaturized Pork Loins, Followed by Lab-Scale Validation That Confirmed Tested Compounds Do Not Show Synergistic Effects against Salmonella Typhimurium. Foods 2023, 12, 4034. [Google Scholar] [CrossRef]
- Muloiwa, M.; Nyende-Byakika, S.; Dinka, M. Comparison of unstructured kinetic bacterial growth models. S. Afr. J. Chem. Eng. 2020, 33, 141–150. [Google Scholar] [CrossRef]
- Mansouri, A.; Embarek, G.; Kokkalou, E.; Kefalas, P. Phenolic profile and antioxidant activity of the Algerian ripe date palm fruit (Phoenix dactylifera). Food Chem. 2005, 89, 411–420. [Google Scholar] [CrossRef]
- Liyana-Pathirana, C.M.; Shahidi, F. Antioxidant and free radical scavenging activities of whole wheat and milling fractions. Food Chem. 2007, 101, 1151–1157. [Google Scholar] [CrossRef]
- Re, R.; Nicoletta, P.; Anna, P.; Ananth, P.; Min, Y.; Catherine, R.-E. Antioxidant activity applying an improved ABTS radical cation decolorization assay. Free. Radic. Biol. Med. 1999, 26, 1231–1237. [Google Scholar] [CrossRef]
- Pierre, G.; Salah, R.; Gardarin, C.; Traikia, M.; Petit, E.; Delort, A.-M.; Mameri, N.; Moulti-Mati, F.; Michaud, P. Enzymatic degradation and bioactivity evaluation of C-6 oxidized chitosan. Int. J. Biol. Macromol. 2013, 60, 383–392. [Google Scholar] [CrossRef]
- Korica, M.; Mihajlovski, K.; Mohan, T.; Kostić, M. Films based on TEMPO-oxidized chitosan nanoparticles: Obtaining and potential application as wound dressings. Carbohydr. Res. 2024, 542, 109203. [Google Scholar] [CrossRef] [PubMed]
- Boligon, A.A.; Machado, M.M.; Athayde, M.L. Technical Evaluation of Antioxidant Activity. Med. Chem. 2014, 4, 517–522. [Google Scholar] [CrossRef]
- Ouamnina, A.; Alahyane, A.; Elateri, I.; Abderrazik, M. Phenolic composition, antioxidant capacity, and antiglycation potential of select Moroccan date varieties: Promising sources for functional food development. Euro-Mediterr. J. Environ. Integr. 2024, 9, 745–760. [Google Scholar] [CrossRef]
- Ouamnina, A.; Alahyane, A.; Elateri, I.; Boutasknit, A.; Abderrazik, M. Relationship between Phenolic Compounds and Antioxidant Activity of Some Moroccan Date Palm Fruit Varieties (Phoenix dactylifera L.): A Two-Year Study. Plants 2024, 13, 1119. [Google Scholar] [CrossRef]
- Kiliç, I.; Yeşiloğlu, Y. Spectroscopic studies on the antioxidant activity of p-coumaric acid. Spectrochim. Acta Part A Mol. Biomol. Spectrosc. 2013, 115, 719–724. [Google Scholar] [CrossRef]
- Schaich, K.M.; Tian, X.; Xie, J. Hurdles and pitfalls in measuring antioxidant efficacy: A critical evaluation of ABTS, DPPH, and ORAC assays. J. Funct. Foods 2015, 14, 111–125. [Google Scholar] [CrossRef]
- Yen, M.T.; Yang, J.H.; Mau, J.L. Antioxidant properties of chitosan from crab shells. Carbohydr. Polym. 2008, 74, 840–844. [Google Scholar] [CrossRef]
- Luo, Y.; Wang, Q. Recent advances of chitosan and its derivatives for novel applications in food science. J. Food Process. Beverages 2013, 1, 13. [Google Scholar]
- Aouadi, A.; Saoud, D.H.; Rebiai, A.; Laouini, S.E.; Achouri, A.; Zaater, A.; Abdullah, J.A.A. Valorizing shrimp shell chitosan: A versatile biomaterial for fabricating effective antibacterial and antioxidant silver nanoparticles. J. Sol-Gel Sci. Technol. 2024, 112, 752–767. [Google Scholar] [CrossRef]
- Ivashkiva, L.N.; Salomatina, E.V.; Apryatina, K.V.; Markin, A.V.; Sologubov, S.S.; Mochalova, A.E. Terpolymers of chitosan with acrylamide and sodium salt of acrylic acid as prospects flocculants and sorbents. Polym. Bull. 2024, 82, 1–20. [Google Scholar] [CrossRef]
- da Silva, S.B.; Krolicka, M.; van den Broek, L.A.; Frissen, A.E.; Boeriu, C.G. Water-soluble chitosan derivatives and pH-responsive hydrogels by selective C-6 oxidation mediated by TEMPO-laccase redox system. Carbohydr. Polym. 2018, 186, 299–309. [Google Scholar] [CrossRef] [PubMed]
Disclaimer/Publisher’s Note: The statements, opinions and data contained in all publications are solely those of the individual author(s) and contributor(s) and not of MDPI and/or the editor(s). MDPI and/or the editor(s) disclaim responsibility for any injury to people or property resulting from any ideas, methods, instructions or products referred to in the content. |
© 2025 by the authors. Licensee MDPI, Basel, Switzerland. This article is an open access article distributed under the terms and conditions of the Creative Commons Attribution (CC BY) license (https://creativecommons.org/licenses/by/4.0/).







